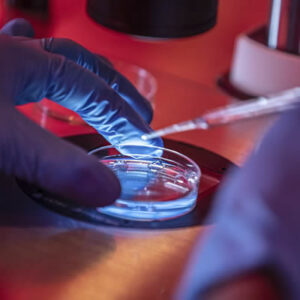

¿Qué es la ICSI?
¿Qué se puede hacer cuando la Fecundación In Vitro (FIV) no tuvo el resultado esperado? La medicina reproductiva tiene una alternativa más sofisticada que puede ayudar a las parejas a lograr el objetivo del embarazo. Se trata del ICSI.
ICSI es una técnica de fecundación asistida para tratar casos de infertilidad. Consiste en microinyectar directamente un espermatozoide al óvulo. Se denomina ICSI a la Inyección Intracitoplasmática de Espermatozoides, por su sigla en inglés. Muchas parejas que no logran un embarazo con los otros procedimientos recurren a este método por su mayor eficacia.

¿En qué casos está indicada la Inyección Intracitoplasmática de Espermatozoides?
Etapas de la Inyección Intracitoplasmatica de Espermatozoides (ICSI)
Estimulación Ovárica
 La estimulación ovárica consiste en aplicar hormonas para obtener más óvulos que en un ciclo natural. Esto permite generar más embriones y seleccionar los de mejor calidad para aumentar las probabilidades de embarazo. El tratamiento dura en promedio entre 10 y 12 días.
La estimulación ovárica consiste en aplicar hormonas para obtener más óvulos que en un ciclo natural. Esto permite generar más embriones y seleccionar los de mejor calidad para aumentar las probabilidades de embarazo. El tratamiento dura en promedio entre 10 y 12 días.Aspiración folicular
 Tras la estimulación ovárica se realiza la aspiración folicular, un procedimiento ambulatorio y sin dolor bajo sedación que dura entre 10 y 30 minutos. Los óvulos se extraen con una aguja mediante aspiración de los folículos y la paciente reposa un par de horas. Si no produce óvulos, se puede recurrir a donación.
Tras la estimulación ovárica se realiza la aspiración folicular, un procedimiento ambulatorio y sin dolor bajo sedación que dura entre 10 y 30 minutos. Los óvulos se extraen con una aguja mediante aspiración de los folículos y la paciente reposa un par de horas. Si no produce óvulos, se puede recurrir a donación.Inseminación de ovocitos y cultivo de embriones
Cada óvulo maduro obtenido es inyectado con un único espermatozoide previamente capacitado de la pareja. La fecundación de los óvulos se determina 16-20 horas después de la inyección.
Cada óvulo maduro obtenido es inyectado con un único espermatozoide previamente capacitado de la pareja. La fecundación de los óvulos se determina 16-20 horas después de la inyección.
Aquellos fecundados normalmente son cultivados en medios especiales para el desarrollo embrionario hasta estadío de blastocisto (día 5/6 de desarrollo) bajo condiciones adecuadas y controladas en el laboratorio. Uno o máximo dos embriones en día 5/6 del desarrollo, serán transferidos al útero de la paciente.
Transferencia embrionaria
 Con un catéter se introducen uno o dos embriones al útero en un proceso que tarda entre 10 a 15 minutos. La paciente puede volver a su casa tras un breve reposo.
Con un catéter se introducen uno o dos embriones al útero en un proceso que tarda entre 10 a 15 minutos. La paciente puede volver a su casa tras un breve reposo.Prueba de embarazo
 Con un análisis se sangre, realizado entre 12 a 14 días después de la transferencia embrionaria, es posible determinar si hay un bebé en camino. Y a los 21 días se podrá realizar la primera ecografía del nuevo ser.
Con un análisis se sangre, realizado entre 12 a 14 días después de la transferencia embrionaria, es posible determinar si hay un bebé en camino. Y a los 21 días se podrá realizar la primera ecografía del nuevo ser.